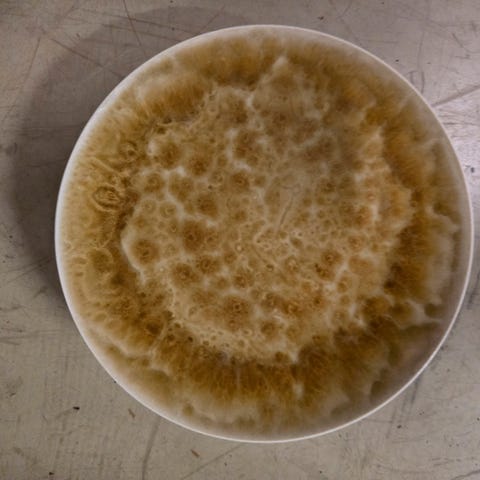

Fiks ferdig
200 kr
Tilstand: Som ny - Ikke synlig brukt
Et sett med store (diameter 26 cm) og små (diameter 20,5 cm) tallerkener fra IKEA:
Små tallerkener: 12stk
Store tallerkener: 10stk
Uten bruksmerker.

Du må være logget inn for å se brukerprofiler og sende meldinger.
Logg innSist endret: 6.1.2026 kl. 14:25 ・ FINN-kode: 444796318